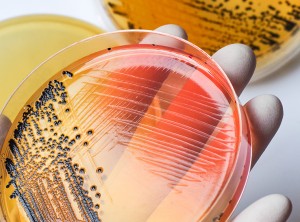
Môi trường tăng sinh Salmonella

Vi sinh vật trong sữa: 7 mối đe dọa lớn nhất đối với sản xuất sữa
05:00 22/03/2026Ngày 1 tháng 6 là Ngày Sữa Thế giới: một lý do chính đáng để tìm hiểu kỹ hơn về thức uống ngon miệng này, một thức uống rất bổ dưỡng nhưng cũng là nơi...
Test PCR phát hiện vi khuẩn gây bệnh trong thực phẩm
23:39 19/12/2025Trong hệ thống quản lý an toàn thực phẩm (HACCP, ISO 22000, BRC, FSSC 22000), các vi khuẩn gây bệnh như Salmonella, Listeria monocytogenes,...
Môi trường tăng sinh Salmonella
03:51 03/05/2025Dưới đây là bài viết chi tiết về môi trường tăng sinh Salmonella, bao gồm phân loại, vai trò và phương pháp sử dụng từng loại môi trường.
Các loại vi sinh vật trong nước và phương pháp kiểm nghiệm vi sinh trong nước
03:48 15/02/2025Các loại vi sinh vật trong nước và phương pháp kiểm nghiệm vi sinh trong nước thường tuân theo các tiêu chuẩn như QCVN (Quy chuẩn Việt Nam), ISO,...
Môi trường nuôi cấy Salmonella
21:30 08/11/2024Salmonella là một loại vi khuẩn gây bệnh phổ biến, thường được tìm thấy trong thực phẩm và gây ra các bệnh liên quan đến đường tiêu hóa như viêm ruột...